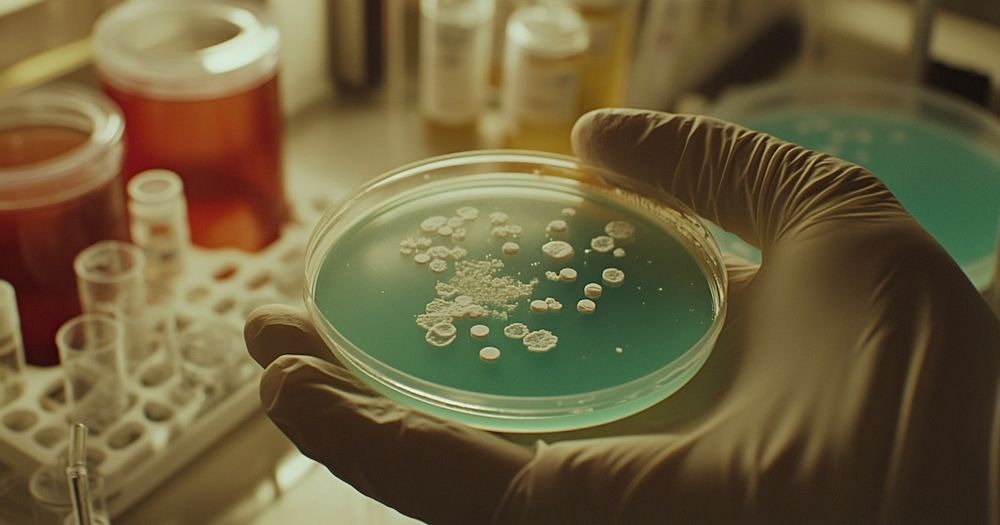

Henry Brubaker
@henrybrubaker.bsky.social
1.5K followers
790 following
7.3K posts
Thomas O Murton: http://en.wikipedia.org/wiki/Tom_Murton
γνωθι σεαυτόν (Conócete a ti mismo) LIFE WON'T WAIT
We need Degrowth
Always Gulf of Mexico
Reflexiones en: alcaidebrubaker.wordpress.com
Hijo y nieto de ferroviario 🚂
Posts
Media
Videos
Starter Packs
Pinned
EL PAÍS
@elpais.com
· 16h

Cronología de la crisis de las mamografías: la Junta de Andalucía reacciona año y medio después de conocer los primeros casos
El “plan de choque” presentado por la Junta de Andalucía es recibido con escepticismo por las mujeres afectadas de cáncer de mama y los sindicatos
social.elpais.com
Reposted by Henry Brubaker
Reposted by Henry Brubaker
Infobae
@infobae.bsky.social
· 18h
Descubren bacterias que “simulan su muerte” para evitar ser eliminadas de hospitales e instalaciones de la NASA
Un equipo de científicos identificó un microorganismo resistente cuya capacidad para permanecer inadvertido en ambientes sometidos a los más estrictos controles de limpieza desafía protocolos tradicionales y plantea nuevas preocupaciones sobre la seguridad
dlvr.it








